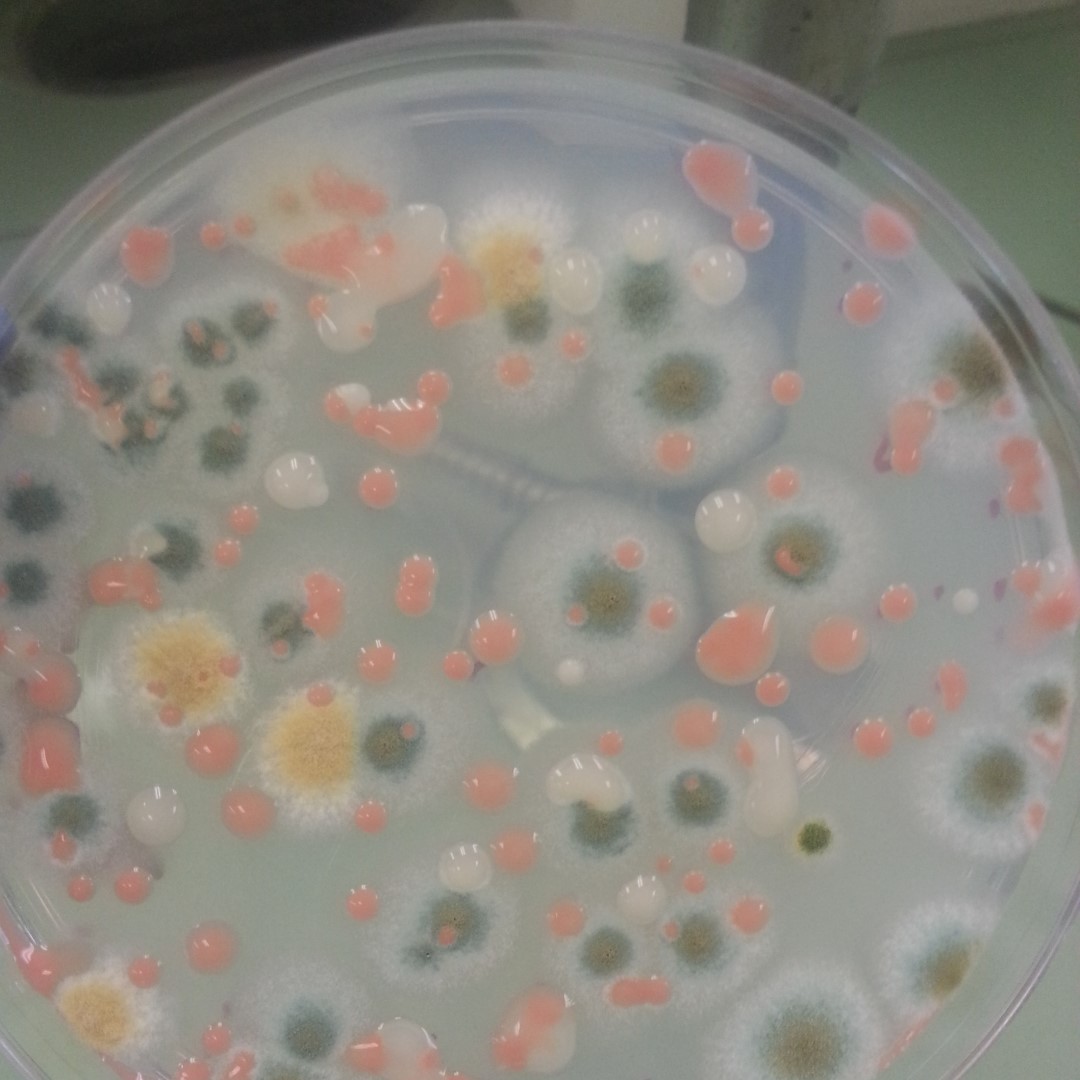

Dangerous fungal spores can surf the stratosphere—and survive
On May 7, 2025, scientists reported that they have captured fungal spores cruising in the inhospitable environment of the stratosphere, much higher than commercial aircraft fly.
Although spores and microbes have been detected in the stratosphere before, the new results come from a cheap, homespun sampling device dangled from weather balloons. More regular sampling could help researchers figure out what traits and conditions allow spores to survive in the stratosphere and how they get up there in the first place.
The work could also be a first step toward an atmospheric monitoring system that could nip emerging fungal pathogens in the bud. The study’s authors reported their work at a conference of the European Geosciences Union (EGU). When brought back to the lab, the researchers found that some of the spores—including pathogens of plants and people—had survived intercontinental trips and could be cultured in the lab.
Spores are to fungi what seeds are to plants. Exceptionally resilient, they can travel great distances on winds before falling back to Earth, often in raindrops. Lab experiments suggest spores can even survive in the stratosphere, a layer of the atmosphere that begins about 10 kilometers up, where temperatures are frigid and air pressure is suffocatingly low.
Most of the stratosphere is also above the ozone layer, so it’s unprotected from DNA-shredding ultraviolet radiation. If spores really could survive up there, it could help explain how fungi—including pathogens that sicken plants—often hop between continents on a kind of stratospheric superhighway.
Tags:
Source: Science
Credit:
